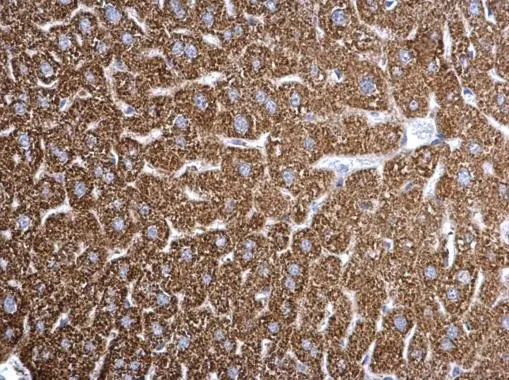
ETFA antibody detects ETFA protein at mitochondria on mouse liver by immunohistochemical analysis. Sample: Paraffin-embedded mouse liver. ETFA antibody (GTX105155) dilution: 1:500. 
 Antigen Retrieval: Trilogy? (EDTA based, pH 8.0) buffer, 15min

ETFA antibody detects ETFA protein by Western blot analysis. A. 30 μg PC-12 whole cell lysate/extract 10 % SDS-PAGE ETFA antibody (GTX105155) dilution: 1:1000
ETFA antibody
GTX105155
ApplicationsImmunoFluorescence, ImmunoPrecipitation, Western Blot, ImmunoCytoChemistry, ImmunoHistoChemistry, ImmunoHistoChemistry Paraffin
Product group Antibodies
ReactivityHuman, Mouse, Rat
TargetETFA
Overview
- SupplierGeneTex
- Product NameETFA antibody
- Delivery Days Customer9
- Application Supplier NoteWB: 1:500-1:3000. ICC/IF: 1:100-1:1000. IHC-P: 1:100-1:1000. IP: 1:100-1:500. *Optimal dilutions/concentrations should be determined by the researcher.Not tested in other applications.
- ApplicationsImmunoFluorescence, ImmunoPrecipitation, Western Blot, ImmunoCytoChemistry, ImmunoHistoChemistry, ImmunoHistoChemistry Paraffin
- CertificationResearch Use Only
- ClonalityPolyclonal
- Concentration0.88 mg/ml
- ConjugateUnconjugated
- Gene ID2108
- Target nameETFA
- Target descriptionelectron transfer flavoprotein subunit alpha
- Target synonymsEMA, GA2, MADD, electron transfer flavoprotein subunit alpha, mitochondrial, alpha-ETF, electron transfer flavoprotein alpha subunit, electron transfer flavoprotein, alpha polypeptide, epididymis secretory sperm binding protein, glutaric aciduria II, multiple acyl-CoA dehydrogenase deficiency
- HostRabbit
- IsotypeIgG
- Protein IDP13804
- Protein NameElectron transfer flavoprotein subunit alpha, mitochondrial
- Scientific DescriptionETFA participates in catalyzing the initial step of the mitochondrial fatty acid beta-oxidation. It shuttles electrons between primary flavoprotein dehydrogenases and the membrane-bound electron transfer flavoprotein ubiquinone oxidoreductase. Defects in electron-transfer-flavoprotein have been implicated in type II glutaricaciduria in which multiple acyl-CoA dehydrogenase deficiencies result in large excretion of glutaric, lactic, ethylmalonic, butyric, isobutyric, 2-methyl-butyric, and isovaleric acids. Two transcript variants encoding different isoforms have been found for this gene. [provided by RefSeq]
- ReactivityHuman, Mouse, Rat
- Storage Instruction-20°C or -80°C,2°C to 8°C
- UNSPSC12352203
References
- Suzuki K, Kubota Y, Kaneko K, et al. CLPX regulates mitochondrial fatty acid β-oxidation in liver cells. J Biol Chem. 2023,299(10):105210. doi: 10.1016/j.jbc.2023.105210Read this paper